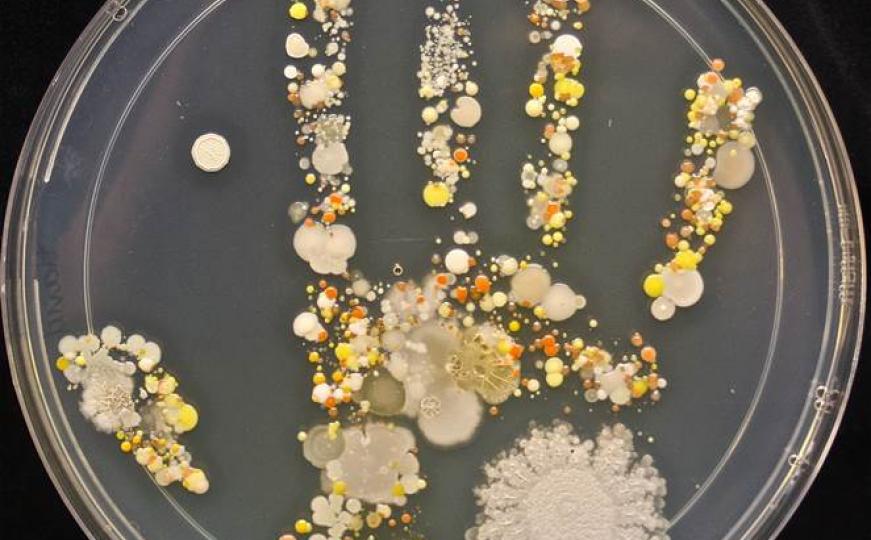

Top lista najprljavijih: Deset stvari koje imaju najviše bakterija na sebi
Lovci na bakterije, članovi Higijenskog vijeća Turske su napravili listu deset najprljavijih stvari u 2015. godini. Kriterij je bio jednostavan, najveći broj bakterija na sebi, javlja Anadolu Agency (AA).
Neki od predmeta se nalaze u svakodnevnoj upotrebi. To su prvenstveno otvori za usta na limenkama pića, rukohvati u javnim toaletima, namještaj u restoranima brze hrane, novčanice, rukohvati stepenica, meniji u restoranima i kafićima, česme u zajedničkim prostorijama, pisak za nargilu koji koristi više osoba, posude za led koje se neredovno održavaju, kao i peškiri i oprema u frizerskim salonima i salonima ljepote.
Vijeće čine, pored zdravstvenih radnika i ljudi kao što su nutricionisti, inžinjeri poljoprivrede, kao i članovi udruženja za zaštitu potrošača.
Cilj istraživanja o skupljanju bakterija jeste zaštiti ljude i pomoći im u održavanju higijene.

Radiosarajevo.ba pratite putem aplikacije za Android | iOS i društvenih mreža Twitter | Facebook | Instagram, kao i putem našeg Viber Chata.





